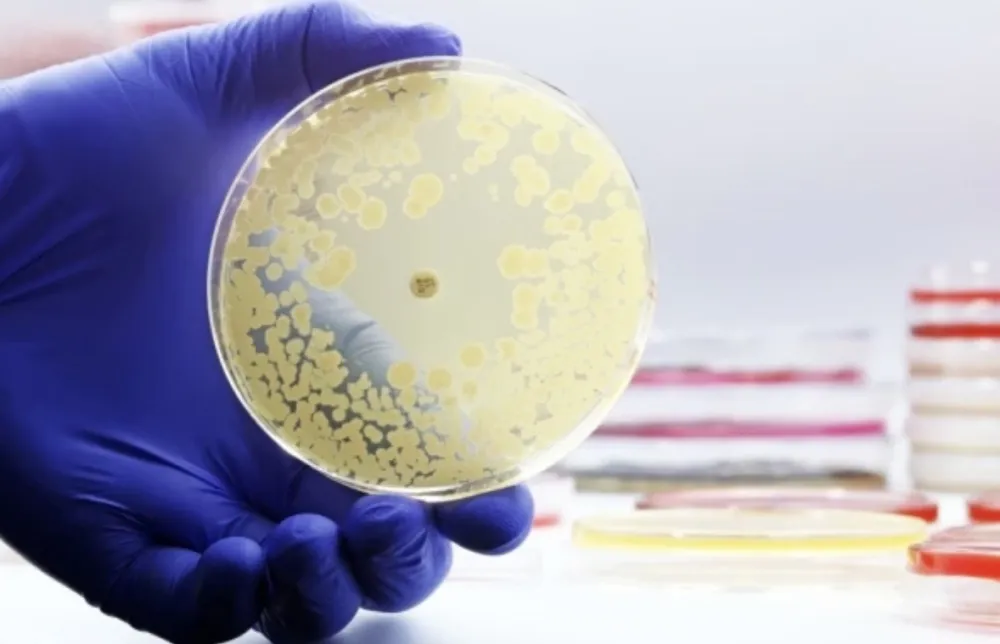
Gori nego &scaron;to se mislilo: Dejstvo antibiotika &scaron;tetno i do osam godina

Preuzmite našu aplikaciju
PRATITE NAS NA
PRIDRUŽITE NAM SE NA VIBER
COMMUNITY
PRATITE NAS
I NA TELEGRAM KANALU
PRATITE NAS
I NA WHATSUP KANALU
Gori nego što se mislilo: Dejstvo antibiotika štetno i do osam godina
Svaki ciklus korišćenja antibiotika može dugoročno da ošteti korisne bakterije u organizmu, a nova studija Univerziteta u Upsali pokazuje da ti efekti mogu da traju i do osam godina, navodi se u časopisu "Nature Medicine".
Iako su antibiotici od ključnog značaja za liječenje infekcija, pored uobičajenih neželjenih dejstava, oni mogu da unište i korisne bakterije u organizmu, dok istovremeno doprinose razvoju rezistentnih "loših" bakterija, prenijela je ANSA.
Istraživači sa Univerziteta u Upsali analizirali su podatke iz švedskog registra ljekova i povezali ih sa detaljnom mapom crijevnog mikrobioma 14.979 odraslih osoba.
"Vidjeli smo da upotreba antibiotika prije četiri do osam godina i dalje utiče na sastav trenutnog mikrobioma. Za neke vrste antibiotika, čak i jedan ciklus ostavlja tragove", rekao je autor studije Gabrijel Baldanzi.
Istraživači su primijetili da efekti nisu isti za sve antibiotike navodeći da klindamicin, fluorohinoloni i flukloksacilin izazivaju najveće promjene u mikrobiomu, dok je penicilin V, imao minimalan i kratkotrajan efekat.
Koordinator studije, Tuve Fal, istakao je da rezultati pružaju važne kliničke smjernice. "Studija može da pomogne u definisanju budućih preporuka za upotrebu antibiotika, posebno kada se bira između dva jednako efikasna lijeka, od kojih jedan ima slabiji uticaj na crijevni mikrobiom".
Preuzmite našu aplikaciju
PRATITE NAS NA
PRIDRUŽITE NAM SE NA VIBER
COMMUNITY
PRATITE NAS
I NA TELEGRAM KANALU
PRATITE NAS
I NA WHATSUP KANALU










